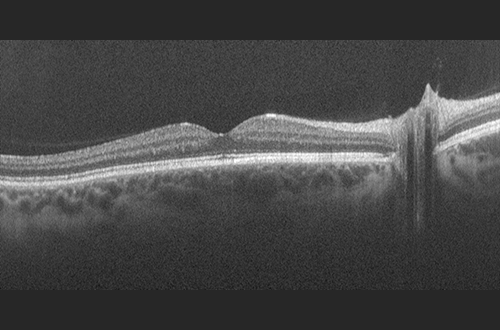

Download Images and Logos
Usage Guidelines
Please read the Logo usage guidelines for using the Optos logo. By downloading and using any of the Optos product images, you acknowledge that you understand and agree to the following Image Usage Agreement.
optomap Images and OCT Images
optomap images are created using one of our ultra-widefield imaging devices. Images for each modality are included below. If you would like a more specific optomap image, please visit our complete Image Library for more optomap images.
Device Usage Images
Images of optomap ultra-widefield devices in use